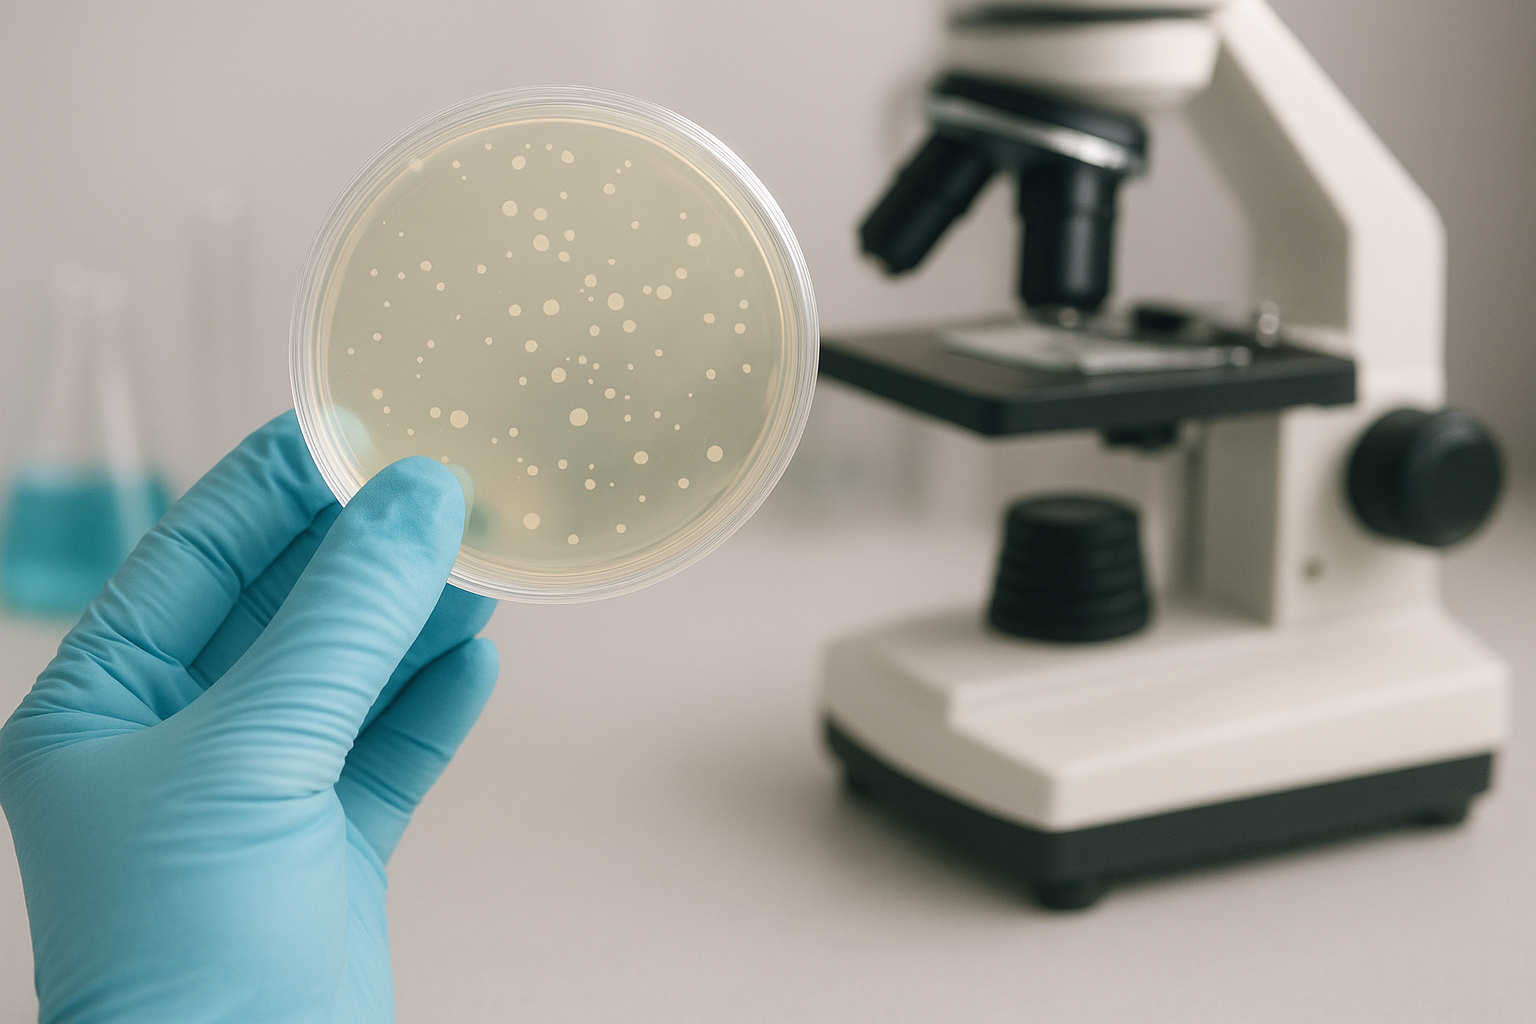

Analyses microbiologiques
Les analyses microbiologiques alimentaires sont indispensables pour vérifier la conformité des produits par rapport aux réglementations d’hygiène en vigueur.
Elles doivent évaluer les flores pathogènes et d’altération présentes dans les aliments. Grâce à l’utilisation de méthodes et d’équipements à la fine pointe de l’innovation, notre laboratoire de microbiologie est en mesure de vous offrir des services variés et adaptés à vos besoins.
Nous réalisons des analyses microbiologiques complètes pour différentes catégories d’aliments ainsi que sur des écouvillons environnementaux afin de valider l’efficacité du nettoyage de vos équipements et structures.
Nos équipes vous assurent un accès accéléré aux résultats des analyses. De plus, nous offrons un service de prélèvement d’échantillons.
Elles doivent évaluer les flores pathogènes et d’altération présentes dans les aliments. Grâce à l’utilisation de méthodes et d’équipements à la fine pointe de l’innovation, notre laboratoire de microbiologie est en mesure de vous offrir des services variés et adaptés à vos besoins.
Nous réalisons des analyses microbiologiques complètes pour différentes catégories d’aliments ainsi que sur des écouvillons environnementaux afin de valider l’efficacité du nettoyage de vos équipements et structures.
Nos équipes vous assurent un accès accéléré aux résultats des analyses. De plus, nous offrons un service de prélèvement d’échantillons.
Nos services d’analyses microbiologiques :
- Microorganismes à 30°C (FMAT)
- Coliformes totaux à 30°C
- Coliformes thermotolérants à 44°C
- Enterobacteriaceae
- Entérocoques Intestinaux
- Staphylocoques à coagulase positive à 37°C
- Escherichia Coli β-glucoronidase
- Escherichia Coli β-glucoronidase par la technique NPP
- Bactéries sulfito-réductrices à 37°C et 46°C
- Clostridium perfringens
- Bactéries lactiques mésophiles à 30°C
- Bacillus cereus présomptifs à 30°C
- Levures et moisissures
- Salmonella spp
- Salmonella spp (Recherche) par PCR
- Listeria spp et monocytogenes (Recherche)
- Listeria spp et monocytogenes (Recherche) par VIDAS
- Listeria spp et monocytogenes (Recherche) par PCR
- Listeria spp et monocytogenes (Dénombrement)
- Vibrio spp (Parahaemolyticus, Cholerae et Vulnificus)
- Cronobacter spp
- Activité de l’eau Aw
- Test de stabilité et stérilité des conserves végétales et animales
News Letter
Sign up to receive the latest posts from us
not found get_subscription_form_html5
Si vous rencontrez des problèmes similaires,
veuillez nous contacter
(+212) 522 26 72 42